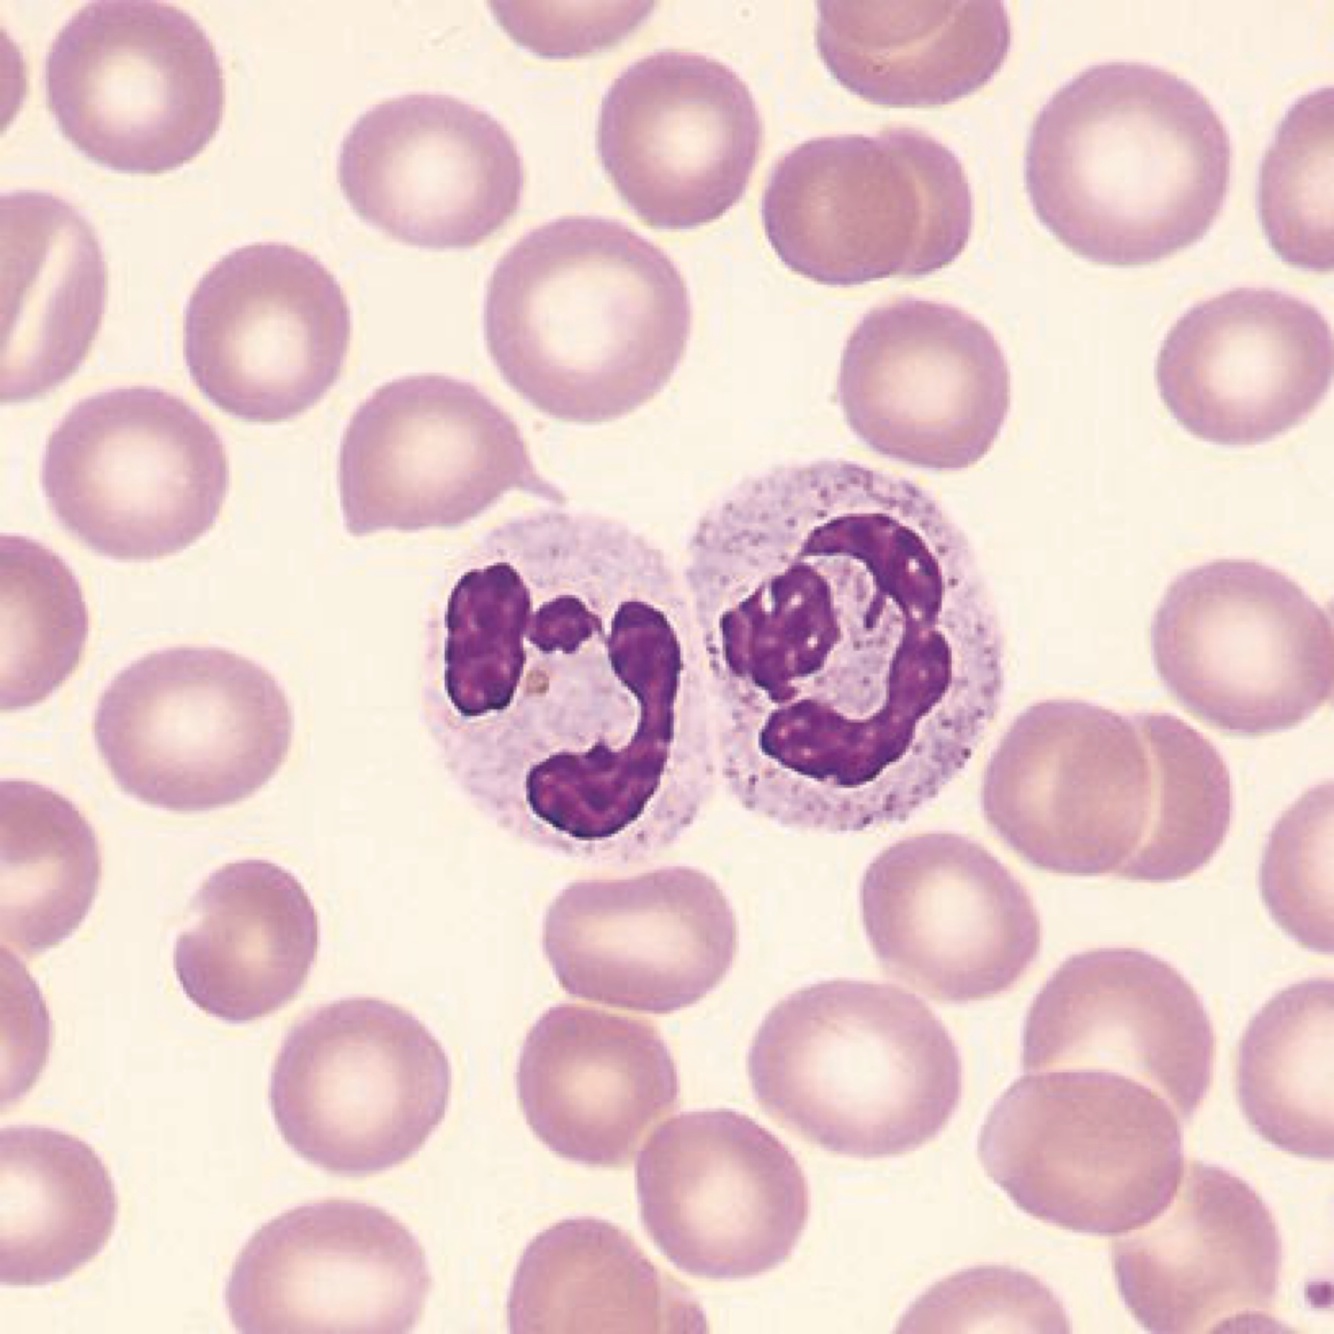

Purpose of blood
Regulation- temperature, ph, blood volume
Transportation- oxygen to cells, transporting waste out, hormones to their target receptors
Protection- prevebting blood loss by clotting, preventing infection
What is hematopoiesis
Production of all blood cells
Where does hematopoiesus occur?
Red bone marrow
What are the leukocyte categories? And what’s the difference?
Granulocytes- have obvious granules
Agranulocytes- do not have onvious granules
What cells are granulocytes?
Neutrophils, basophils, eosinophils
What cells are agranulocytes?
Lymphocytes and monocytes
What is this?
Neutrophil Granulocyte Most abundant granulocyte Multi lobed nucleus Phagotize bacteria
What is this?

Basophil Granulocyte Bilobed nucleus Large purplish-black granules Release histamines Fight inflammation
What is this?

Eosinophil (eskimo wears earmuffs) Granulocyte Bilobed nucleus Red granules Kill parasitic worms Helps with allergies and asthema
What is this?

Lymphocyte Agranulocyte Spherucal or indented nucleus Pale blue cytoplasm Serves as part of the immune system Latches onnand destroys viruses or bacteria
What is this

Monocyte Agranulocyte U or kidney shaped nucleus Gray-blue cytoplasm Phagocytosis Develop into macrophages or dendrites in tissues
What is this?

Erythrocyte Red blood cell Biconcave Salmon colored Transport oxygen and carbon dioxide
What is this?

Platelets Discoid cytoplasmic fragments containing granules Stain deep purple Seal small tears in blood vessels Instrumental in blood clotting Developed from ruptured megakaryocytes
What is the difference between antibodies and antigens?
Antigens- molecules capable of stimulating an immune response (current intruder)
Antibodies- Y-shaped proteins produced by B cells of the immune system in response to exposure to antigens. (Body is immune now)
Universal blood donor?
O-
Universal blood recipient?
AB+
Normal RBC count?
Men- 4.35-5.65 million per microliter
Women- 3.92-5.13 million per microliter
Blood clotting elements?
THROMBOPOIETIN- hormone that regulates formation of platelets
PLATELETS
PROTHROMBIN-converts to thrombin
THROMBIN- combines with FIBRINOGEN to to produce FIBRIN
FIBRINOGEN-soluble protrin thats converted to insoluble FIBRIN during clotting
FIBRIN- fibrous insoluble protein formed during clotting
Formed elements of blood
Erythrocytes- RBC
Leukocytes- WBC
Thrombocyte- platelets
What are 3 types of circulation?
Pulmonary circulation- heart to lungs to heart
Systemic- heart to heart
Coronary- supplies blood to heart cells
Body cavity for heart?
Mediastinum
Linings for the heart?
Whole: Pericardium
Innermost- endocardium
Middle- Myocardium
Outermost- Epicardium
Pace maker for the heart?
SA Node
Route conduction in the heart
SA node SV node AV bundle Bundle branches Purkinje fibers


